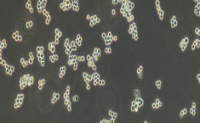
RAMOS Cells

万千商家帮你免费找货
0 人在求购买到急需产品
- 详细信息
- 文献和实验
- 技术资料
- 库存:
5×105/株
- 供应商:
康朗生物
- 细胞类型:
细胞系
- 组织来源:
人
- 相关疾病:
见说明书
- 物种来源:
人
- 免疫类型:
见说明书
- 细胞形态:
见说明书
- 是否是肿瘤细胞:
是
- 器官来源:
见说明书
- 运输方式:
常温/干冰
- 年限:
见说明书
- 生长状态:
贴壁/悬浮
- 规格:
1ml/株
Description
Astrocyte Medium-animal (AM-a) is a complete medium designed for optimal growth of normal animal (rat or mouse) astrocytes in vitro. It is a sterile, liquid medium which contains essential and non-essential amino acids, vitamins, organic and inorganic compounds, hormones, growth factors, trace minerals and a low concentration of fetal bovine serum (2%). The medium is bicarbonate buffered and has a pH of 7.4 when equilibrated in an incubator with an atmosphere of 5% CO2/95% air. The medium is formulated (quantitatively and qualitatively) to provide a defined and optimally balanced nutritional environment that selectively promotes growth of normal human astrocytes in vitro.
Components
AM-a consists of 500 ml of basal medium, 10 ml of fetal bovine serum (FBS, Cat. No. 0010), 5 ml of astrocyte growth supplement-animal (AGS-a, Cat. No. 1882) and 5 ml of penicillin/streptomycin solution (P/S, Cat. No.0503). Please see the preparation procedures below for the final assembly of the medium
Product Use
AM-a is for research use only. It is not approved for human or animal use, or for application in in vitro diagnostic procedures.
Storage
Store the basal medium at 4°C, the AGS, the FBS and the P/S solution at -20 °C. Protect from light.
Shipping
Dry ice.细胞培养的过程中,经常见到黑色的颗粒或小黑点,这种情况是怎么引起的呢?该怎么避免呢?
星形胶质细胞培养基-动物 原 因:
黑点,大概有细胞本身带的,环境有的,还有人身上带进细胞间的,还有就是血清和培养基
1、如果小黑点有增殖趋势,那么就有可能是污染了,需要处理;
2、如果小黑点没有增殖趋势,且不影响细胞生长,也不影响实验的话,则可能
a、是“黑胶虫”,黑胶虫究竟是一种生物还是非生物,本身就存在争议。有人认为是从血清中来的一种原虫,也有人认为是细菌,或是真菌,也有人认为是血清中的蛋白的结晶。“黑胶虫”可寄生于动物细胞,也可以生存于培养基中,依靠细胞和培养基中的营养为生,并随细胞传代而传代。“黑胶虫”与细胞竞争性生长,开始时对细胞并没有什么影响,但当黑胶虫的数量多到一定程度的时候, 细胞生长就会受到影响直至死亡,严重影响了科研活动的开展和进行。以前(这个至少是10年以前),很多实验室在养细胞时用国产血清,那时的血清可能质量不过关,有所谓的“黑胶虫”,但是也没有明确的鉴定。但是现在的血清,即使国产的,产品里这种现象就少见了。
b、是细胞碎片,或血清里德沉淀析出,在做布朗运动。
c、是核糖体,也可能是杂质
星形胶质细胞培养基-动物 支原体污染及检测方法
(1).支原体污染在细胞培养中最常见、不易被查觉,但支原体污染可显著影响细胞功能干扰实验结果。支原体是介于细菌和病毒之间的目前所知能独立生活的最小微生物,它无细胞壁,形态呈高度多形性,最小直径0.2um,可通过滤器。
支原体在污染细胞后,它通过影响细胞的DNA、RNA 的合成及急速消耗培养基中的氨基酸来抑制细胞的生长,并能降低细胞的融合率。因此,在运用各种细胞系进行实验研究时,首先要证明所用细胞有无支原体的污染。
细胞经过严格质控,不含有细菌、真菌、病毒(HIV、HBV、HCV)、支原体。
(2).支原体污染后,培养基可不发生浑浊,细胞病变轻微或不明显,因此难以发现。目前,支原体检测的方法有以下几种。
(a).相差显微镜观察;
(b).低张处理地衣红染色法;
(c).荧光染色法;
(d).酶标法;
(e).PCR法:基础医学细胞中心使用该方法进行检测。
优点:灵敏度高,检测耗时短,样品量小
(只需50ul细胞培养用液上清)。
缺点:引物及制剂费用较高。
星形胶质细胞培养基-动物细胞特点:
1.传代情况:P2
2.活性好、稳定性高、适应性强,易培养
3.传代快、多:2-3天传一代,普通可传10代以上 肿瘤细胞无限制
4.纯度高达95% 无污染和其他杂细胞
5.有技术疑问可以提供一对一的解答:专业,及时,耐心
6.货期短,一般冻存管5-7个工作日,复苏7-15个工作日。
★由于细胞库现有细胞类目多,为了不出现混乱错误,需要了解相关细胞价格及详细资料请老师联系我们,对您造成的不便还请见谅!
★注:如运输过程中导致细胞污染或者死亡,我们将无条件补发
收货后十个工作日内有其他问题提供照片可半价重发
星形胶质细胞培养基-动物 保藏细胞防万一
最后,通过低温保藏储备一些细胞,以防支原体大面积来袭。如果支原体有抬头的迹象,或常规检测呈阳性结果,那么最可靠的补救措施是扔掉所有培养物,清洁培养箱和超净台,一切从头开始。当然,你得确保储备的细胞是不含支原体的。933 MesenFectagen? 间充质干细胞转染试剂盒 Mesenchymal Stem Cell Transfection Kit 250 Transfections
0943 AstroFectagen? 星形胶质细胞转染试剂盒 Astrocyte Transfection Kit 250 Transfections
0953 SMCFectagen? 平滑肌细胞转染试剂盒 Smooth Muscle Cell Transfection Kit 250 Transfections
0963 KeratoFectagen? 角质细胞转染试剂盒 Keratinocyte Transfection Kit 200 Transfections
0973 EpiFectagen II? 上皮细胞转染试剂盒 Epithelial Cell Transfection Kit 250 Transfections
Cell Based Assay
"Angiogenesis
" 血管生成检测试剂盒
8158 IVTFA 体外管腔形成分析试剂盒 In Vitro Tube Fomation Assay (Angiogenesis Assay) 50 tests/96 well plate
"Cell-Adhesion
" 细胞粘附试剂盒
8008 Col I型胶原细胞粘附检测试剂盒 Collagen I Cell Adhesion Assay 48 tests/48 well plate
8018 Fibro 纤维粘连细胞粘附检测试剂盒 Fibronectin Cell Adhesion Assay 48 tests/48 well plate
8178 C3DGK 胶原I-3D凝胶试剂盒 Collagen I-3D Gelling Kit 100 mg
8188 CCCSCK 胶原I-细胞培养表面包被试剂盒 Collage I-Cell Culture Surface Coating Kit 10 mg
"Cell-Viability-and-Apoptosis
" 细胞活力与凋亡检测试剂盒
8028 MTT MTT细胞活力和增殖检测试剂盒 MTT Cell Viability and Proliferation Assay 1000 tests/96 well plate
8038 WST WST-1细胞活力和增殖检测试剂盒 WST-1 Cell Viability and Proliferation Assay 1000 tests/96 well plate
8058 CSA 细胞衰老检测试剂盒 Cell Senescence Assay 50 tests/53 mm plate
8078 LDH LDH细胞毒性检测试剂盒 LDH Cytotoxicity Assay 500 tests/96 well plate
8088 TUNEL TUNEL色标法细胞凋亡检测试剂盒 Colorimetric TUNEL Apoptosis Assay 50 tests/96 well plate
8138 CSK 活/死细胞检测试剂盒 Live/Dead Cell Staining Kit 1000 tests/96 well plate
8228 CAS 细胞凋亡蛋白酶-3分析试剂盒 Caspase-3 Assay 100 tests
"Microbial-Detection
" 微生物检测试剂盒
8208 MYCO 支原体PCR检测试剂盒 Mycoplasma PCR Detection Kit 100 tests
"Enzyme Activity Kits
" 酶活力检测试剂盒
8068 GalC β-半乳糖苷酶比色检测试剂盒 Beta-Galactosidase Colorimetric Assay 50 tests/53 mm plate
8078 LDH LDH细胞毒性检测试剂盒 LDH Cytotoxicity Assay 500 tests/96 well plate
8108 NPP 硝基苯酸钠(pNPP)磷酸酶检测试剂盒 pNPP Phosphatase Assay 500 tests/96 well plate
风险提示:丁香通仅作为第三方平台,为商家信息发布提供平台空间。用户咨询产品时请注意保护个人信息及财产安全,合理判断,谨慎选购商品,商家和用户对交易行为负责。对于医疗器械类产品,请先查证核实企业经营资质和医疗器械产品注册证情况。
文献和实验完全用化学成分明确的培养基诱导、培养 hPSC。 虽然这些技术都在进步,建立 hPSC 培养系统仍有以下一个或多个不利因素: ● 使用超过生理水平的大量的生长因子 ● 含有人源或动物源性物质 ● 依赖动物来源的或成分不完全明确的 ECM PromoCell hPSC 生长培养基 DXF 消除了这些不利因素,不仅是纯化学定义/无异源性的,也完全不含有人源或动物源性物质。此外,培养基中添加的生长因子的浓度在较低的生理范围内。最佳的培养环境是生长过程易于控制的、稳定
浅谈 RNA 测序:从阿尔茨海默症相关星形胶质细胞的发现说起
信号传导的基因均表达上调。值得注意的是,在 AD 和 WT 中都发现高 GFAP 星形胶质细胞群,特异性表达了与血管相关的星形胶质细胞的标记物,例如 Aqp4。DAA 表达了一组独特的基因,包括参与胞吞作用、补体级联和衰老的基因。为将 DAA 与先前描述的星形胶质细胞特征相关联,该研究检测了来自大数据的 RNA 集。发现与野生型相比,AD 模型小鼠中,星形胶质细胞总体上具有广泛反应性,炎症相关的 A1 星形胶质细胞表达增加,但 A2 型星形胶质细胞信号没有显示增加。通过在 WT 和 5xFAD 动物的海马
1.材料和方法1.1 DMEM/F12条件培养液(亚硒酸钠40μg·L-1,腐胺16.2 mg·L-1,转铁蛋白100 mg·L-1,胰岛素234U·L-1,甲状腺素0.4μg·L-1,黄体酮0.62 mg·L-1,谷氨酰胺3g·L-1)。DMEM/F12培养基、小牛血清购自Hyclone公司,兔抗鼠GC抗体、亚硒酸钠、腐胺等购自Sigma公司。1.2 视神经胶质细胞的来源、培养 取新生2d的Wistar大鼠10只(第三军医大学大坪医院野战外科研究所动物中心提供),无菌条件下取出双
技术资料暂无技术资料 索取技术资料